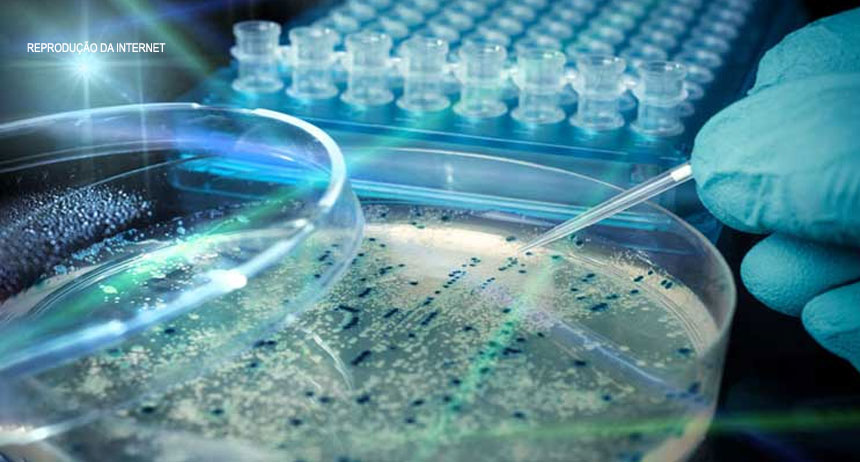

Dia Mundial da Sepse chama atenção para o problema
Nessa quarta-feira, 13 de setembro, é celebrado o Dia Mundial da Sepse, organizado no Brasil pelo Instituto Latino-americano de Sepse (Ilas). Antigamente chamada de septicemia ou infecção generalizada, a sepse é uma inflamação generalizada do próprio organismo contra uma infecção que pode estar localizada em qualquer órgão. Essa inflamação pode levar à parada de funcionamento de um ou mais órgãos, com risco de morte quando não descoberta e tratada rapidamente.
Segundo o instituto, a sepse é atualmente a principal causa de mortes nas unidades de terapia intensiva (UTI), matando mais do que infarto do miocárdio e alguns tipos de câncer. O Brasil tem uma das mais altas taxas de mortalidade do mundo pela sepse. Estima-se que 400 mil novos casos são diagnosticados por ano e 240 mil pessoas morrem anualmente. Um dos fatores para os altos índices de letalidade é o desconhecimento da população e o atendimento médico tardio.
Embora não existam sintomas específicos, todas as pessoas que estão passando por uma infecção e apresentam febre, aceleração do coração (taquicardia), respiração mais rápida, fraqueza intensa e tonteiras – além de pelo menos um dos sinais de gravidade como pressão baixa, diminuição de quantidade de urina, falta de ar, sonolência excessiva ou confusão mental (principalmente os idosos) – devem procurar imediatamente um serviço de emergência ou seu médico. O principal tratamento da sepse é por meio de antibióticos. Podem ser necessários oxigênio, líquidos na veia e medicamentos que aumentem a pressão arterial. A diálise pode ser necessária se os rins pararem de funcionar. Um aparelho de respiração artificial pode ser utilizado em caso de dificuldade respiratória grave.
A campanha promovida em 13 de setembro visa a chamar atenção de profissionais de saúde e público em geral, a fim de promover o conhecimento científico e melhorar a percepção e o tratamento da sepse. Acesse www.diamundialdasepse.com.br e participe do movimento.
Fonte: Coren-DF